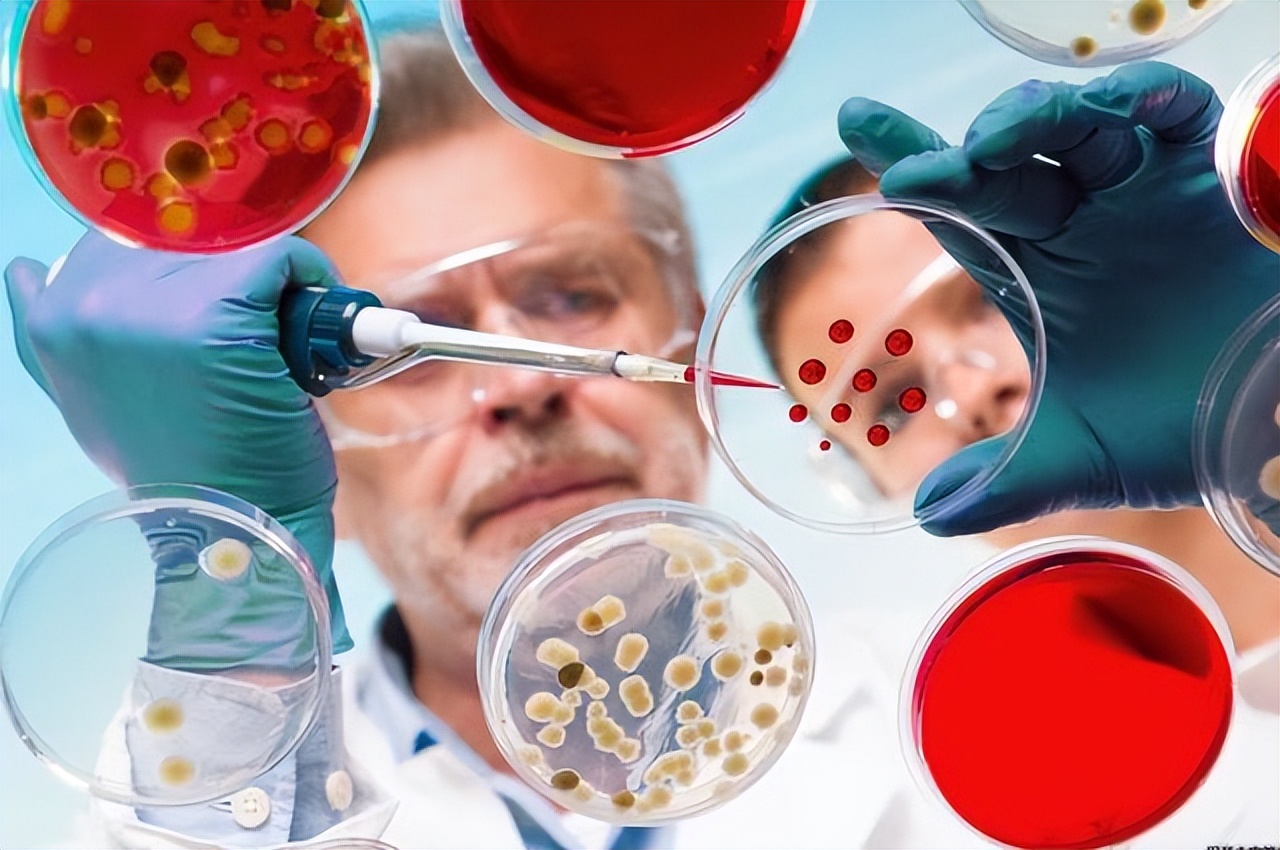
癌症一旦有症状是不是已经晚期了,癌症并不是真正意义上的疾病

癌症是人们避之唯恐不及的一种疾病,之所以癌症如此可怕,是因为大多数癌症的发病十分隐匿,早期难以发现。
即使身体出现一些不适症状,也很容易被人忽视,当症状明显,不得不去医院治疗时,病情往往发展到中晚期,大大增加了治疗难度,错过了最佳治疗时机。
其实只要在生活中足够细心,就能发现癌症的蛛丝马迹,比如你在生活中发现以下异常表现,很可能是癌症的信号,一定要及时看医生,明确病情。

癌症来临前,身体可能有4个异常表现
身体消瘦
如果体内有癌细胞,这些癌细胞需要抢夺体内的营养,以达到强身健体的目的。随着大量营养的消耗,患者的身体会逐渐消瘦。
所以,如果平时不刻意减肥,但是身体无缘无故的瘦了,要警惕是不是癌症引起的。
除了体重减轻,还可能伴有食欲不振、头晕、乏力、消化不良等症状,也应引起足够的警惕。
疼痛
身体的很多组织器官都可以作为癌细胞安营扎寨的地方,癌细胞生根后,肿瘤的增大可侵犯周围的器官和组织,或对血管和神经造成压迫,可引起相应部位的疼痛。
所以,如果发现身体某个部位有疼痛感,而且长时间没有改善,药物治疗刚开始有一些效果,但是逐渐失控,疼痛感越来越严重,就要引起足够的重视。
莫名的出血
很多癌症早期都有出血的症状,比如咯血,要警惕肺癌的发生。便血,防范大肠癌的发生;
不明原因阴道出血的女性要警惕子宫内膜癌和宫颈癌;出现血尿时,要警惕肾癌、膀胱癌等疾病。
此外,牙龈出血、流鼻血、皮肤充血等,应该引起注意。

身体出现肿块
很多癌症的首发表现是肿块,如乳腺癌、甲状腺癌等,因此,当乳房、颈部、鼻腔、腹部等部位发现肿块时,且长期不消退,有加重趋势,很可能是癌症,要及时去医院检查,排除癌症。
想要及时发现癌症,不仅要多关注自己的身体变化,还要注意定期到医院体检,体检可以发现很多身体上的小问题,及时处理,防止发展成大问题。
尤其是对于癌症的高危人群,更应该重视每年的体检。必要时还要做癌症筛查,及时发现早期癌症,减少癌症对身体的伤害。
癌症等于绝症?
现在癌症发病率比较高,但是治愈率不高,因为早期发现不够及时,早期癌症并不可怕,80%~90%是可以治愈的。

我国每年新发癌症病例超过300万例,其中80%以上发生在50岁以上,大多数早期癌症可以通过手术根除,并存活很长时间。
早期胃癌5年生存率91%以上,早期宫颈癌10年生存率94%以上,早期乳腺癌治愈率95%以上,大肠癌息肉顶端癌变切除治愈率96%以上,部分“小肝癌”患者术后仍存活20年以上。
患者身体若有4个表现,病情或已好转,请继续坚持
1、疼痛明显减轻
癌症最大的特点就是疼,时轻时重,疼起来甚至晚上失眠,严重影响日常生活。

在治疗过程中,如果感觉疼痛明显减轻,身体得到放松,这说明治疗起到了一定的作用,遏制了病情的发展,这个时候你一定要坚持治疗,继续保持好转的迹象。
2、癌变细胞数量减少
相对来说,治疗的不同阶段会有不同的体检,如果癌细胞数量比上次检查时明显减少,说明对癌症的治疗非常有效,请继续坚持,癌症慢慢好了。
3、肿瘤标志物的变化
查血液看肿瘤标志物的变化,可以简单判断疗效,比如查鼻咽癌的EBV DNA,结直肠癌的CEA,前列腺癌的PSA,肝癌的AFP等,如果与治疗前相比水平下降,则病情正在好转。

但是,有时候也会出现一些矛盾的现象,与CT或MRI相比,肿瘤缩小了,血检肿瘤标志物增加了,此时应以图像结果为准。
4、检查指标好转
如果想知道癌症有没有好转,可以通过一些检查指标来判断,比如影像学、肿瘤标志物等,在癌症治疗过程中,还会定期进行肿瘤影像学检查,如超声、MR、CT等,监测疗效。
如影像学检查显示肿瘤缩小或消失,原有胸腔或腹腔积液减少等,这些都表明治疗是有效的,病人体内的癌细胞正在缩小。